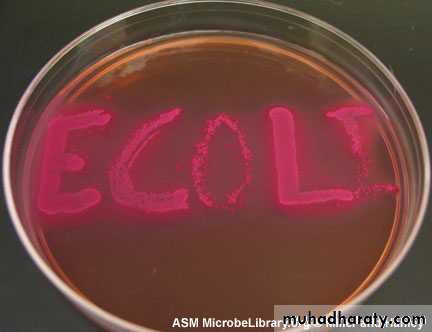
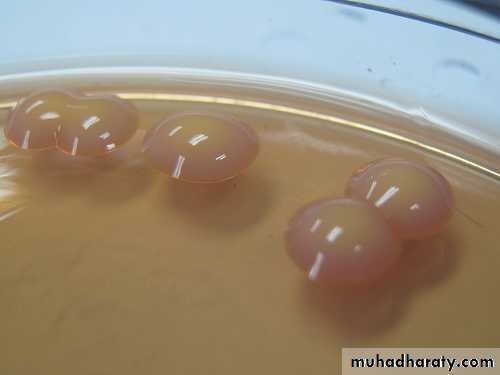
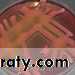
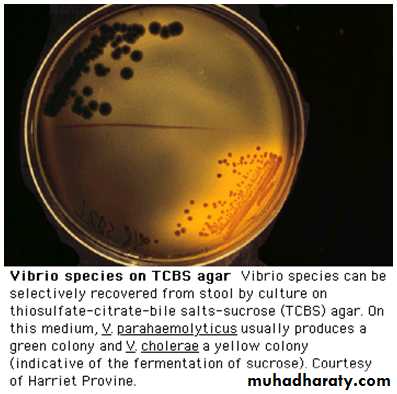
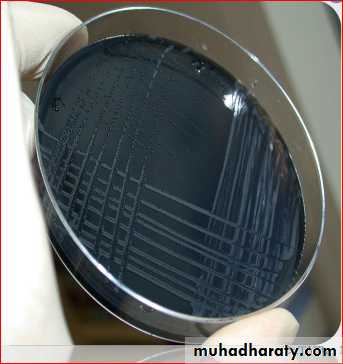

ENTEROBACTERIACEAE
Dr.T.V.Rao MD1
General characteristics of enterobacteriaHabitat
Found in the human gut, at a density of approximately 109 cells per gram of faeces.However, the predominant species in the gut is Bacteroides.
Up to 15% of the population may harbour enterobacteria in the oral cavity, mostly as transient commensals.Their oral carriage rate may increase in old age, and in states leading to reduced salivary flow (xerostomia)
Characteristics
Rapidly growing cells 2×0.4 µm in size; may appear coccobacillary.Many species are motile and possess a capsuleespecially on initial isolation.
All species are endotoxigenic because of the lipopolysaccharide outer cell wall.
They also possess pili and flagella, which mediate adhesion and locomotion, respectivelyPathogenicity
All Enterobacteriaceae are potentially pathogenic.Patients who are immunosuppressed, undergoing mechanical or medical manipulation, and have underlying disease are mostsusceptible to infection.
Endotoxin shock
This can be precipitated in humans by the lipopolysaccharide, which all Enterobacteriaceae release when they aredestroyed.Toxic lipopolysaccharide comprises lipid A, the core polysaccharide and the O antigen;
the lipid A is responsible for most of the symptoms associated with endotoxicshock.The toxic effects of lipopolysaccharide are many and include fever, hypotension, intravascular coagulation andeffects on the immune system. Large doses of endotoxin maycause death.
Eschericheae
The tribe Eschericheae includes five genera: Escherichia, Salmonella, Shigella, Edwardsiella and Citrobacter.The most important human pathogens in this group, Escherichia coli and the Salmonella and Shigella species
Escherichia coli
Habitat and transmissionIndigenous commensal of the human intestinal tract; transmission is either endogenous or exogenous.
CharacteristicsGram-negative rods, motile, sometimes capsulate, facultative anaerobe, bile-tolerant.
ESCHERICHIA COLI
9
Pathogenicity
E. coli is a major agent of sepsis; it causes the following diseases.
Urinary tract infectionYoung women and elderly adults are the most susceptible.
The disease varies from simple urethritis to seriouspyelonephritis.
Diarrheal diseases
These range from simple diarrhea to severe disease leading to excessive fluid loss and dehydration, which may be fatal in malnourished infants and elderly debilitated adults.Many strains of enteropathogenic E. coli have powerful toxins and other mechanisms by which they cause diarrhea:
Enterotoxins: mainly two types, both coded byplasmids, one is heat-labile (LT) and is similar inaction to the cholera toxin, and the other is heat-stable(ST).• Enteroinvasiveness: some strains have the ability toinvade intestinal epithelial cells and causeinflammation.• Adhesive factors are produced by some strainsenabling adhesion to mucosae; termed ‘colonizationfactor antigens’, these are mediated by plasmid-codedpili.
• Vero cytotoxicity is caused by strains that have the ability to induce cytopathic effects on Vero cells (grown in tissue culture).
Verotoxin (VT) producers can cause diarrhea with hemorrhagic symptoms (e.g. E. coli O157).
Based on the above, diarrhea-producing E. coli can be divided into five types:
1. enteropathogenic E. coli (EPEC)2. enteroinvasive E. coli (EIEC)3. enterotoxigenic E. coli (ETEC)4. enterohaemorrhagic E. coli (EHEC)5. enteroaggregative E. coli (EAEC).
Neonatal meningitis and septicaemia
Other infections E. coli may cause include neonatal meningitis, septicaemia and wound infection, particularly after surgery of the lower intestinal tractSalmonellae
Salmonella spp.Habitat and transmissionLeading sources of salmonella infection are poultry products (i.e. flesh and eggs) and pet turtles (in the USA).
Occupational salmonellosis affects veterinary and slaughterhouse workers.
Infection is by ingestion of contaminated food, or person-to-person via the fecal–oral route.The carrier state, which develops in some after infection, is an important source of organisms
Characteristics
Gram-negative, motile, non-sporing rods.All except S. typhi are non-capsulate; facultative anaerobes .
PathogenicityThe major types of salmonellosis (diseases due to Salmonella) are enteric fever, gastroenteritis and septicaemia.
Enteric fever (typhoid fever)Caused by S. typhi or S. paratyphi A, B or C .
GastroenteritisThe most common form of salmonellosis, and can be dueto any of the S. enteritidis serotypes. Symptoms appear 10–24 h after ingestion of highly contaminated food or beverage. Nausea, vomiting, abdominal cramps, headache anddiarrhoea are common.
SepticaemiaFrequently caused by Salmonella dublin or Salmonella choleraesuis; a fulminant, sometimes fatal disease independent of intestinal symptoms. Pneumonia, meningitis and osteomyelitis may result from haematogenous spread of the bacteria
• Treatment and prevention
Proper cooking of foods derived from animal sources.
Typhoid vaccine, a killed suspension of S. typhi, is available for those travelling to or living in areas where typhoid fever is endemic.
Shigellae
Shigella spp.Habitat and transmissionThe only reservoir is the human intestine. Infection is spread by the faecal–oral route under crowded conditions.
A minute dose of the organisms is adequate to cause disease.
CharacteristicsGram-negative, non-motile rods (compare salmonellae);non-capsulate.Pathogenicity
Although shigellae do not invade systemically like salmonellae, they locally invade the intestinal epithelium (ileum and colon).The resultant intense inflammatory response is characterized by bloody, mucopurulent diarrhoea (dysentery).
Although no enterotoxin is produced, the exotoxin ofShigella species is neurotoxic
Treatment and prevention
Severe dysentery is managed by fluid and electrolyte replacement.
Antibiotics should be avoided as many strains are resistant to multiple antibiotics.
Spread can be controlled by improving sanitation and personal hygiene to interruptfecal–oral transmission; hand hygiene is critical.Klebsielleae
A number of species belonging to this tribe, namely Klebsiella, Enterobacter and Serratia, are indigenous to the human intestinal and respiratory tracts.
They are also occasionally isolated from the oral cavity and hence are considered transient oral commensals.
They cause serious disease in immunocompromised patients, especially in hospital environments (nosocomial infection).
Klebsiella pneumoniae
As the name indicates, Klebsiella pneumoniae may sometimes cause a severe destructive pneumonia.It also causes nosocomial urinary tract infection. The virulence of the organism is mainly due to its large anti phagocytic capsule.
This species is isolated from the oropharynx or gastrointestinal tract of about 5% of healthy people, and the isolation rate is higher in the hospitalized
KLEBSIELLA - on CULTURE
Dr Praveg Gupta MD
28Enterobacter spp.Enterobacter species are indigenous to the intestinal tract but can be found on plants and as free-living saprophytes.
They may cause nosocomial urinary tract infection and very rarely a primary infection.
Enterobacter cloacae and Enterobacter aerogenes are the most frequently isolated as transients in the oral cavity.
Serratia spp..
It may occasionally cause fatal disease in neonates,and in immunosuppressed and debilitated individualsSerratia
Pseudomonas
Pseudomonas species are not enterobacteria, but they are included in this chapter for convenience as they are Gram negative rods with somewhat similar properties.The genus contains a large number of species, but only a few are human pathogens.
They are widely distributed in the environment and may cause disease, especially in hospital settings.Pseudomonas aeruginosa is the most important species to cause such infection and is a special problem in burns patients
Pseudomonas aeruginosa
Habitat and transmissionColonizes the human intestine in a few healthy individuals and in a large proportion of hospitalized patients.Colonizes environmental surfaces, especially under moist conditions.
Thus, they are found in dental unit water lines, as harmless saprophytes.CharacteristicsAerobic, Gram-negative rods, motile by means of polar flagella.
Grow over a very wide temperature range, including room temperature.Pathogenicity
Virulence factors identifed include lipopolysaccharide endotoxin,an exotoxin, extracellular proteases and elastases, and an extracellular ‘slime’ that prevents phagocytosis
Treatment and prevention
Although this species is resistant to most antimicrobials, it is sensitive to aminoglycosides and certain β-lactams(e.g. acylureidopenicillins), cephalosporins and polymixin.Prevention is by good asepsis in hospitals and rational antibiotic therapy (to prevent emergence of resistant isolates)Vibrios, campylobacters
VibriosThe genus Vibrio includes two important human pathogens, but their natural habitat is water.
Vibrio cholerae causes cholera, while Vibrio parahaemolyticus causes a less severe diarrhoea.
The main symptom of cholera is watery diarrhoea
that can be fatal as a result of severe dehydration, water and electrolyte lossVibrio choleraeHabitat and transmissionThe habitat is water contaminated with faeces of patients or carriers; there is no animal reservoir.
A life-threatening, watery diarrhoea (rice-water stools) is the characteristic disease
Modes of Transmission
Water (infectious dose = 109)Food (infectious dose = 103)
Person-to-person
41
CharacteristicsGram-negative slender bacilli, comma-shaped with pointed ends.
Highly motile by means of a single polar flagellum.May be seen directly in stool samples by dark-field microscopy.
Pathogenicity
V. cholerae has the ability to colonize the intestinal tractThe cells attach to but do not invade the intestinal mucosa.
Pathogenicity is due to secretion of an enterotoxin, which binds to ganglioside receptors on mucosal cells.After a lag period of 15–45 min, adenylate cyclase is activated and the cyclic adenosine monophosphate concentration inside the intestinal cells increases.
This in turn leads to excretion of electrolytes and water and subsequent diarrhoea, leading to severe dehydrate
Pathophysiology of cholera
Most people remain asymptomatic. The symptoms of cholera include :
Signs & SymptomsComplications
Treatment and preventionIntravenous administration of fluids and electrolytes is essential for recovery.
Oral administration of a solution containing glucose and electrolytes (oral rehydration therapy) is successful.
Antibiotics (usually tetracycline) do not affect the disease outcome once the enterotoxin attaches to the intestinal cells, but they prevent subsequent attacks by reducing the number of toxin-producing V. cholerae cells in the intestine.
Vibrio parahaemolyticu
This vibrio requires a relatively high salt concentration for growth and is distributed worldwide in marine environments, for example, in South-East Asia.A common agent of acute enteritis associated with the consumption of improperly cooked seafood
Campylobacters
Campylobacter jejuniis the major human pathogenic species;
Campylobacter rectus
has been isolated from active periodontal disease sites and has been implicated as a periodonto pathogen.
Campylobacter spp.Habitat and transmission
The natural reservoir is animals.Organisms are acquired from contaminated food and milk
Characteristics
Curved, seagull-shaped, Gram-negative rods; mobile with a single polar flagellum.Blood-free, c harcoal-based selective
medium agar (CSM) for isolation ofCampylobacter jejuni
Pathogenicity
Gastroenteritis, especially in children, is the most commonhuman infection caused by Campylobacter species.It resembles dysentery and is usually self-limiting, but may last for several days.
The heat-labile enterotoxin of Campylobacter fetus is implicated. Campylobacters may occasionally cause bacteraemia, meningitis, endocarditis, arthritis and urinary tract infection.
C. jejuni has been implicated as the aetiological agent of Guillain–Barr syndrome.
Some strains of C. rectus isolated from periodontal disease sites produce a cytotoxin and stimulate human gingival fbroblasts to produce interleukins-6 and -8
Fusobacteria, Leptotrichia andspirochaetes
Fusobacteria are non-sporing, anaerobic, non-motile, nonor weakly fermentative, spindle-shaped bacilli (with fused ends: hence the name).
They are normal inhabitants of the oral cavity, colon and female genital tract and are sometimesmisolated from pulmonary and pelvic abscesses.
• Fusospirochaetal infections, which they cause in combination with spirochaetes, are noteworthy. Fusobacterium nucleatum (the type species), Fusobacterium periodontium and Fusobacteriumsimiae are isolated mainly from periodontal disease sites, and others such as Fusobacterium alocis and Fusobacterium sulci are sometimes found in the healthy gingival sulcus.
• Non-oral species include Fusobacterium gonidiaformans, Fusobacterium russii and Fusobacterium ulcerans
Spirochaetes are a diverse group of spiral, motile organisms
comprising fve genera. Of these, three genera are humanpathogens:
• Treponema causes syphilis, bejel, yaws, pinta and, in the
oral cavity, acute necrotizing ulcerative gingivitis
(together with fusobacteria)
• Borrelia causes relapsing fever and Lyme disease
• Leptospira causes leptospirosis.Spirochaetes are helical organisms with a central protoplasmic cylinder surrounded by a cytoplasmic membrane
Spirochaetes
The cell wall is similar to Gram-negative bacteria but
stains poorly with the Gram stain.Underneath the cell wall run three to five axial filaments that are fixed to the extremities of the organism.
Contractions of these filaments distort the bacterial cell body to give it its helical shape.
The organism moves either by rotation along the long axis or by flexion of cells. Because of their weak refractile nature, dark-ground microscopy is used to visualize these organisms in the laboratory, although immunofluorescence is more useful for
identifcation purposes.